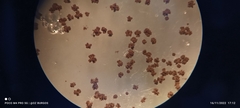
Zygomycota
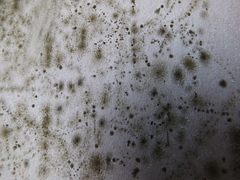
Zygomycota

Zygomycota: taxon details and analytics
- Domain
- Kingdom
- Fungi
- Phylum
- Zygomycota
- Class
- Order
- Family
- Genus
- Species
- Scientific Name
- Zygomycota
Summary description from Wikipedia:
Zygomycota
Zygomycota, or zygote fungi, is a former division or phylum of the kingdom Fungi. The members are now part of two phyla: the Mucoromycota and Zoopagomycota. Approximately 1060 species are known. They are mostly terrestrial in habitat, living in soil or on decaying plant or animal material. Some are parasites of plants, insects, and small animals, while others form symbiotic relationships with plants. Zygomycete hyphae may be coenocytic, forming septa only where gametes are formed or to wall off dead hyphae. Zygomycota is no longer recognised as it was not believed to be truly monophyletic.
...Zygomycota in languages:
- Bokmål
- koplingsopper
- Chinese
- 接合菌門
- Czech
- houby spájivé
- English
- zygote fungi
- Estonian
- ikkesseened
- Finnish
- yhtymäsienet
- German
- Jochpilze
- Hungarian
- járomspórás gombák
- Japanese
- 接合菌門
- Korean
- 접합균문
- Polish
- Sprzężniaki
- Swedish
- kopplingssvampar
- Swedish
- oksvampar
- Thai
- ราสร้างไซโกสปอร์
Images from inaturalist.org observations:
We recommend you sign up for this excellent, free service.
Parent Taxon
Sibling Taxa
- Aphelida
- Aphelidiomycota
- Ascomycota
- Basidiobolomycota
- Basidiomycota
- Blastocladiomycota
- Calcarisporiellomycota
- Caulochytriomycota
- Chytridiomycota
- Entomophthoromycota
- Entorrhizomycota
- Glomeromycota
- Kickxellomycota
- Monoblepharomycota
- Mortierellomycota
- Mucoromycota
- Neocallimastigomycota
- Olpidiomycota
- Prototaxites
- Rozellomycota
- Zoopagomycota
- Zygomycota